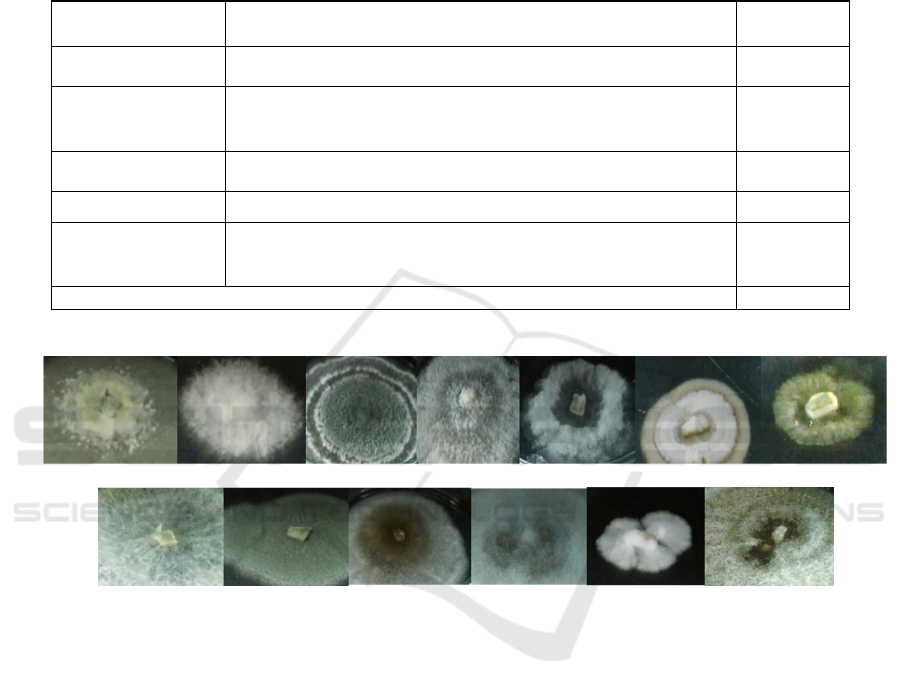

Preli
m
inary Screening of Antagonistic Fungal Endophytes
from Zingiberaceae
Anisa Lutfia
1
, Yurnaliza
1
and Erman Munir
1
1
Department of Biology, Faculty of Mathematics and Natural Sciences, Universitas Sumatera Utara, Medan, Indonesia
Keywords: Endophyte, Fungi, Hutan Sibayak, North Sumatera, Zingiberaceae.
Abstract: Efforts to elaborate the role endophytes have been intensively studied from a different view point
for the last two decades. One of the most encouraging works is to find potential sources for novel
medicinal compounds. Preliminary screening of fungal endophytes possessing antagonistic
activity from rhizomes of Zingiberaceae has been conducted. The aim of this study is to collect
potential antagonistic fungal strains against representative microbial pathogens: Staphylococcus
aureus, Escherichia coli and Candida albicans. Antagonisms assay was performed by agar plug
method in dual culture plate assay. The study found thirty-nine (39) fungal strains collected from
rhizomes of five species of Zingiberaceae namely Alpinia sp., Amomum centrocephalum,
Elettaria sp., Etlingera sp. and Hedychium coronarium. Among all strains tested, 20 of them
were antagonists of S.aureus, 3 of E.coli and 1 of C.albicans. All antagonist strains showed
different degree of inhibitory activities which indicated the different nature of fungal endophytes
and their chemical properties.
1 INTRODUCTION
Zingiberaceae is a family of herbs that grow
abundantly in tropical to subtropical region with
center of divergence located in Southeast Asia. The
medicinal herbs covers about 1400 species around
the region, mainly from Peninsular Malaysia,
Indonesia, Brunei, Singapore, Philippines and New
Guinea (Pandey, 2001). In North Sumatera itself,
about 47 species of Zingiberaceae have been
reported while most of them were known to inhabit
Hutan Sibayak (Siregar, 2008). Notable species like
ginger and turmeric, has long been known as
potential therapy towards some illness and diseases
such as, digestive disorders, fever, cold, cough,
arthritis and muscle cramps (Ma, 2012). In scientific
reports, biological activities from the Zingiberaceae
compounds are proven to act as anti-inflammation,
anti-tumor, anti-apoptosis and antimicrobials
(Karuppiah, 2012).
On the other hand, microbial resistance is a big
challenge on medicinal view point. These ways of
finding may be achieved through the exploitation of
fungal endophytes to synthesize novel antibiotics,
especially the modified or somewhat similar with
Zingiberaceae compounds. The first step to study the
potential fungal endophytes is by isolating some
antagonistic strains from healthy and non-
symptomatic plant parts. Successful isolation of
fungal endophytes have been reported by several
researchers. Antagonistic Penicillium sp. has been
isolated from Curcuma longa, exhibiting inhibitory
activity against Pseudomonas aeruginosa and
Klebsiella pneumoniae (Rathod, 2013). Chemical
compounds produced by culture of Pestalotiopsis
vaccinii were known to be a newly discovered
natural products, solely synthesized by the strain
itself (Wang, 2014; Wang, 2017). As far literatures
has been surveyed, the study on the study on
exploitation of fungal endophytes from
Zingiberaceae is still limited. In this study, we
reported that rhizomes of representative species
from Zingiberaceae in North Sumatera, were
harbored by several strains of fungal endophytes.
The results of antagonistic activity towards tested
pathogens were distinct among fungal strains,
indicating different capability of strains in producing
antimicrobial compounds.
.
42
Lutfia, A., Yurnaliza, . and Munir, E.
Preliminary Screening of Antagonistic Fungal Endophytes from Zingiberaceae.
DOI: 10.5220/0010082300420046
In Proceedings of the International Conference of Science, Technology, Engineering, Environmental and Ramification Researches (ICOSTEERR 2018) - Research in Industry 4.0, pages
42-46
ISBN: 978-989-758-449-7
Copyright
c
2020 by SCITEPRESS – Science and Technology Publications, Lda. All rights reserved

2 MATERIALS AND METHODS
2.1 Plant Materials
Samples of wild Zingiberaceae were collected during
exploration in Hutan Sibayak, located in Deli serdang
district, North Sumatera. Sampling were conducted
incidentally without considering any climate and
spatial factors. Plants anchoring to soils were dug up
and cut to separate its shoots and roots. The root parts
or rhizome were wrapped with paper and stored in
plastic bags. Duplicate samples were collected
separately to be authenticated by Herbarium
Medanese, Universitas Sumatera Utara for
identification. In laboratory, rhizomes were later cut
into smaller segments and composites were made by
pooling segments into one bulk sample for each
species of Zingiberaceae. The samples were then
used in isolation step.
2.2 Isolation of Fungal Endophytes
Step in isolating fungal endophytes were based on
previous report (Yurnaliza, 2014). Bulk samples from
each species of Zingiberaceae were washed with
tap water to remove remaining soil and dirt. The
samples were surface-sterilized by dipping in 75%
ethanol for 2 min, 5.3% NaOCl for 5 min and 75%
ethanol for 30 secs. The pieces were again washed
several times with sterile distilled water to remove
remaining solutions. Samples were dried on Whatman
filter paper and cut into 1–2 smaller pieces. The
pieces were placed on top of Potato Dextrose Agar
(Oxoid™) supplemented with chloramphenicol.
Plates were incubated in ambient condition for 3 days.
Any visible fungal growth from each pieces were
then sub-cultured onto new medium to preserve
the strains. Each fungal strains were differentiated
from their colony appearances.
2.3 Antagonisms Assay of Fungal
Endophytes
Pathogenic strains used in this study were:
Staphylococcus aureus ATCC® 29213™,
Escherichia coli ATCC® 25922™ and clinical
strain of Candida albicans. Both S. aureus and E.
coli were first grown in Nutrient Agar (NA) while C.
albicans in Potato Dextrose Agar (PDA) prior
antagonisms assay. Antagonisms assay were
performed based on agar plug method in dual culture
plate assay (Balouiri, 2016).
Direct colony suspensions from each pathogenic
strains were made by swabbing colonies into sterile
physiological saline solution (0.95% NaCl) to obtain
OD
600
= 0.5. One mililitre of cell suspensions were
mixed with 15 mL molten PDA (45
o
C) medium,
supplemented with 1% (w/v) yeast extracts for
bacteria and 1% peptone (w/v) for C. albicans.
Molten agar medium were then plated to obtain
microbial lawns. Three plugs of aerial mycelium
from each fungal endophytes were placed on top of
medium. Plates were incubated for 2 days in ambient
condition. Clear zones around mycelial plugs
indicating antagonisms were measured using
standard caliper in millimetre unit (mm).
3 RESULTS AND DISCUSSIONS
The species list of Zingiberaceae found in this study
along with its fungal endophytic associates is
presented in Table 1. Previous report revealed that
there were eight genera of Zingiberaceae in Hutan
Sibayak that were: Amomum, Etlingera, Geocharis,
Geostachys, Globba, Hedychium, Hornstedtia and
Zingiber (Siregar, 2008). Although we just managed
to collect five genera in this study, here we reported
two new genera, Alpinia and Elettaria.
From the results, it can be seen that isolated
fungal endophytes were distinct to each species as
shown in Figure 1. Although the isolates were
seemed to be different among others, morphological
characters alone are not enough to identify species
level. Further molecular characterization is needed
to ensure the species identification.
In this study, we successfully isolated 39 fungal
strains with 30% of isolates were from H.
coronarium (13 isolates). Rhizome as being part of
plants’ food reserve is thought to be harbored by
various endophytes. Previous study showed that
between parts like leaf, petiole, stem, root,
adventitious root and rhizome used in isolation of
endophytic fungi from H. coronarium, the rhizome
showed the greatest diversity in number of
culturable fungal strains. Although some exceptions
can be found in other species of Zingiberaceae, that
was Zingiber officinale and Amomum siamense with
most recovered isolates were from petiole and
pseudostem, respectively, rather than from their
rhizomes (Bussaban, 2001; Uzma, 2016).
While several authors have reported the number
of fungal isolates from species of Zingiberaceae,
most of their reports
are about culturable
actinomycetes from genera Alpinia, Curcuma,
Hedychium and Zingiber (Taechowisan, 2003;
Taechowisan 2003; Taechowisan, 2008;
Krishnapura, 2015). Based on our knowing, this is
Preliminary Screening of Antagonistic Fungal Endophytes from Zingiberaceae
43
the first report on succesful isolation of fungal
endophytes from Elettaria. Molecular
identification is needed to confirm the possibility of
finding novel fungal strains from this species and
is our current concerns. Results will be published
elsewhere.
Table 1: Species list of Zingiberaceae and their fungal endophytic associates
Species
Isolate Code
N
umbe
r
of
Isolates
A
lpinia sp.
JRT 1A, JRT 1B, JRT 2A, JRT 2B, JRT 2C, JRT 3A
6
A
momum
centrocephalum
J
RL 1
A
, JRL 1B, JRL 2
A
,
J
RL 2B,
J
RL 2C,
J
RL 2D,
J
RL 3
A
,
JRL 3B , JRL 4A
9
E
tlingera sp.
JRN 1A, JRN 1B, JRN 1C, JRN 2A, JRN 3A, JRN 4A, JRN 4B 7
E
letta
r
ia s
p
.
J
RS 1
A
,
J
RS 1B,
J
RS 1C,
J
RS 2
A
,
J
RS 2B 5
H
edycium
coronarium
J
RD 1
A
,
J
RD 2
A
,
J
RD 2B,
J
RD 2C,
J
RD 2D,
J
RD 3
A
,
J
RE 1
A
,
JRE 1B, JRE 2A, JRE 2B, JRE 4 A, JRE 4B
13
Total
39
Figure 1: Representative colony images of isolated fungal endophytes from Zingiberaceae
Another approach to improve the number of
isolated endophytes from plant parts, is by varying
the medium composition. Endophytic bacteria
isolated from rhizomes of Curcuma zedoaria were
succesfully recovered through the use of four
isolation medium, mainly modified Nutrient Agar
(NA) and Water Yeast Extract Agar (WYEA). The
study also incorporated turmeric extracts itself into
the medium to induce growth of certain endophytic
strains (Krishnapura, 2014).
The results of antagonism assay of fungal
endophytes against three pathogens are presented in
Table 2. Twenty isolates or more than 50% inhibit
S. aureus with various zone measuring from 8.46
to 30.75 mm. Three isolates inhibit E. coli and one
inhibit C. albicans. Among all, JRN 4B enable to
inhibit all tested pathogens. From the results it is
indicated that fungal endophytes from
Zingiberaceae mostly synthesized compounds
effectively against gram positive bacteria. The
analyses of compounds produced by isolates are
now under investigation.
Although majority of tested fungal strains did not
show any inhibition zones in this study, especially to
E. coli and C. albicans, most of them were observed
to grow on top of microbial lawns. We assumed that
this might be some type of interaction or synergisms
between two competing microbes. Since we were
using agar plug method to exhibit inhibitory effect
towards pathogen, it is also possible that the fungal
strains secreted antimicrobial metabolites into its
agar medium. Based on our observation, future study
on evaluating antimicrobial activity of fungal strains
whether from the extracts and culture filtrates, may
support our assumption.
ICOSTEERR 2018 - International Conference of Science, Technology, Engineering, Environmental and Ramification Researches
44

4 CONCLUSIONS
Five species of Zingiberaceae sampled from Hutan
Sibayak, North Sumatera are known to be
inhabited by fungal endophytes. Thirty nine
culturable fungal strains were succesfully isolated
from rhizomes of Alpinia, Amomum, Etlingera,
Elettaria and Hedychium. The study also
reported the first successful attempt on isolating
fungal endophytes from genus Elettaria. Each
fungal strains showed different degree of
antagonisms against S. aureus while most of them
did not show any inhibition against E. coli and C.
albicans. Confirmation on antimicrobial
metabolites secreted by fungal strains will be
considered in future study to evaluate possible
novel antimicrobial compounds.
Table 2:
Diameter of inhibition zones among tested fungal isolates
Code Isolate
D
i
a
m
ete
r
of Inhi
b
i
t
i
on Zone (m
m
)
S. au
r
eus E. coli
C
. albicans
JRS
1A 30,75 - -
1B - - -
1C 11,35 - -
2A - - -
2B - - -
JRD
1A 24,65 - -
2A - - -
2B 8,46 - -
2C 19,55 - -
2D 23,61 - -
3A 23,85 - -
JRE
1A - - -
1B 9,41 - -
2A - - -
2B - - -
4A - - -
4B 18,23 - -
JRT
1A 20,2 - -
1B - - -
2A 10,28 - -
2B 16,13 13,3 -
2C 13,91 - -
3A - - -
JRL
1A 25,2 - -
1B 13,5 - -
2A - - -
2B - - -
2C 20,11 19,23 -
2D 9,51 - -
3A - - -
3B 13,2 - -
4A - - -
JRN
1A - - -
1B - - -
1C - - -
2A 13,06 - -
3A - - -
4A - - -
4B 23,36 14,86 15,77
Preliminary Screening of Antagonistic Fungal Endophytes from Zingiberaceae
45

Figure 2: Representative images of antagonistic (Left) and non-antagonistic (Right)
ACKNOWLEDGEMENTS
The authors would like to express the highest gratitude
to Universitas Sumatera Utara, for funding this
research under scheme of Penelitian Guru Besar
TALENTA-USU year 2017–2018, contract Number:
427/UN5.2.3.1/PPM/KP-TALENTA USU/2018.
REFERENCES
Balouiri, M., Sadiki, M., Ibnsouda, S.K., 2016.
Methods for In Vitro Evaluating Antimicrobial
activity: A Review. Journal of Pharmaceutical
Analysis, Vol. 6, No. 2, 71–79.
Bussaban, B., Lumyong, S.,Lumyong, P., McKenzie,
E.H., Hyde, K.D., 2001. Endophytic Fungi from
Amomum siamense. Canadian Journal of
Microbiology, Vol. 47, No. 10, 943–948.
Karuppiah, P., Rajaram, S., 2012. Antibacterial effect of
Allium sativum cloves and Zingiber officinale rhizomes
against multiple-drug resistant clinical pathogens.
Asian Pac J Trop Biomed, Vol. 2, No. 8, 597–601.
Krishnapura, P.R., Belur, P.D., 2015. Isolation and
Screning of Endophytes from the rhizomes of Some
Zingiberaceae Plant for L- Asparaginase
production. Preparative Biochemistry and
Biotechnology Vol. 46, No. 3, 281–287.
Ma, X., Gang, D.R., 2006. Metabolic Profiling of in vitro
Micropropagated and conventionally Greenhous
Grown Ginger (Zingiber officinale).
Phytochemistry, Vol. 67, No. 20, 2239–2255.
Pandey, B.P., 2001. A Text Book of Botany.
Angiosperms: Taxonomy, Anatomy,
Embryology, S.
Chand & Company. India,
4
th
Edition.
Rathod, V., Singh, D., Ninganagouda, S., Hiremath, J.,
Kulkarni, P., 2013. Biosynthesis Of Silver Nanoparticle
By Endophytic Fungi
Penicillium
sp. Isolated From
Curcuma longa
(turmeric) And Its Antibacterial
Activity Against Pathogenic Gram Negative Bacteria.
Journal of Pharmacy research,
Vol.
7,
448–453.
Siregar, E.S., Pasaribu, N., 2008. Inventarisasi Jenis-
JenisZingiberaceae di Hutan Sibayak
Sumatera Utara.
Jurnal Penelitian MIPA
Vol.2, No. 1,
22–24.
Sulistiyani, T.R., Lisdiyanti, P., Lestari, Y., 2014.
Population and Diversity of Endophytic Bacteria
Associated with Medical Plant
Curcuma zedoaria
.
Microbiology Indonesia,
Vol. 8, No. 2, 65–72.
Taechowisan, T., Peberdy, J.F., Lumyong, S., 2003.
Isolation of Endophytic actinomycetes from selected
plants and their antifungal activity.
World Journal
of Microbiology and Biotechnology,
Vol. 19, No. 4,
381–385.
Taechowisan, T., Lumyong, S., 2003. Activity Of
Endophytic Actinomycetes From Roots Of
Zingiber
officinale
and
Alpinia galanga
Against
Phytopathogenic Fungi.
Annals of Microbiology,
Vol.
53, No. 3, 291–298.
Taechowisan, T., Chuaychot, N., Chanaphat, S.,
Wanbanjob, A., Shen, Y.,
et al
2008. Biological
Activity of Chemical Constituents Isolated From
Streptomyces
sp. Tc025, an Endophyte in
Alpinia
galanga. International Journal of Pharmacology,
Vol.
4, No. 2
,
95–101.
Uzma, F., Konappa, N.M., Chowdappa, S., 2016.
Diversity and Extracellular Enzyme Activites ofM
Fungal
Endophytes
Isolated from Medicinal
plants of Western Ghats, Karnataka.
Egyptian
Journal of Basic and Applied Sciences,
Vol. 3, No. 4,
335–342.
Wang, J., Wei, X., Lu, X., Xu, F., Wan, J., Lin, X., Zhou,
X., Liao, S., Yang, B., Tu, Z., Liu, Y., 2014. Eight
New Polyketide Metabolites From the Fungus
Pestalotiopsis vaccinia
endogenus with the Mangrove
Plant
Kandelia candel
(L) Druce.
Tetrahedron,
Vol.
70, No. 51, 9695–9701.
Wang, J.F., Liang, R., Liao, S.R., Yang, B., Tu, Z.C.,
Lin, X.P., Wang, B.G., Liu, Y., 2017. Vaccinols J-S, ten
new Salicyloid Derivatives from the Marine Mangrove
Derived Endophytic Fungus
Pestalotiopsis vaccinii
.
Fitoterapia,
Vol. 120, 164–170.
Yurnaliza, Aryantha, I.P.G., Esyanti, R.R., Susanto, A.,
2014. Antagonistic Activity Assessment of Fungal
Endophytes From Oil Palm Tissue Against
Ganoderma
boninense
pat.
Plant Pathology Journal
, Vol. 13, No. 4,
257–267.
ICOSTEERR 2018 - International Conference of Science, Technology, Engineering, Environmental and Ramification Researches
46
